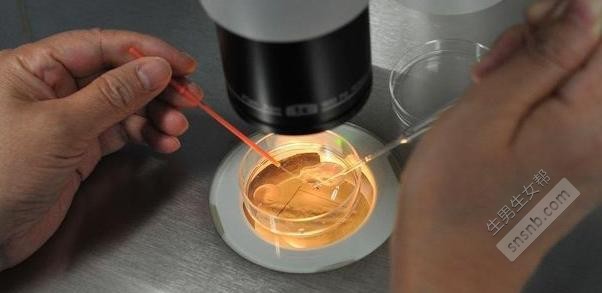

试管婴儿对女性的伤害?对于大部分夫妻来说,都渴望能够拥有一个属于自己的孩子,但随着社会的发展,现在出现不孕不育的人群越来越多,据统计我国不孕人群从20年的3%,已经上涨到了12.5%~15%。 为了解决这一难题,在1978年就诞生出了一项新的技术——试管婴儿,我国在1988年诞生了首例试管宝宝,经过四十多年了,这项技术在不断完善,但其中的辛酸又有多少人知道呢?
 做“试管婴儿”到底有多痛?用九张图剖析全过程 在做试管婴儿之前,男女双方需要进行一次体检,包含血液检查、输卵管状况、B超检查等,过程极为复杂繁琐,尤其是宫颈检查,容易让女性感觉到很不舒服,在检查结果比较合适的情况下,才能够进行试管婴儿的步骤。
 1、正常情况下,女性一个月只能排出一颗卵子,而一次不能保证受孕成功,为了确保试管婴儿的成功率,大夫会给女性注射促排卵针或是服用促排卵药物,来刺激女性的卵巢,以排出更多的卵子,预防胚胎移植移植失败的可能性,也有利于挑选出更加优质的受精卵。 而这促排的药物大多含有激素,容易让人有一些不良的反应,如头晕、恶心、想吐等,甚至诱发卵巢早衰、卵巢囊肿,且促排卵周期一般在8~15天,或是10~14天,但由于每个人的体质不一样,实际的长短会存在着一定的差异。
 2、在B超的监测下,医生会采用一个很长且纤细的针,通过YD穿刺到卵巢内,然后将卵泡抽吸出来,因一次取出的卵子个数较多,在取卵进行前后采取全麻手术,以此来减轻疼痛感,有时需要通过多次穿刺的方式来取卵,容易出血、腹水,甚至是发生感染。 若是取卵量较少,就很可能不会使用麻醉,这样就可能会感觉非常疼痛了,好在这个过程只有10分钟左右。
3、取卵后,大夫会用显微镜进行精子的仔细挑选,然后和卵子放到一起,让精卵通过自然活泼是注射的方式结合,形成受精卵。 ps:受精卵怕光,需要在黑暗的环境下进行挑选。
 4、待受精卵结合后,就会具有了生命力,会被放入到一个特殊的培养皿中进行培养,开始不断的分裂生长,培养液会模拟子宫发育环境,培养师会不断的进行观察调整,直至发育成胚胎。
 5、胚胎培养后,会先采用显微镜进行筛查,挑选出优质的胚胎,然后将挑好的胚胎,采用一个极细的胚胎移植管,在B超的监测下,移植到女性的子宫内。
 6、其它的胚胎会被直接冷冻(零下196℃的液氮)起来,若是遇到特殊的情况,就会停止冷冻。
 7、在胚胎移植到女性体内后,还需要定时注射一些黄体酮或口服黄体酮胶囊来帮助胎儿发育,直至B超可以看到胎心,对孕妈身体又是一番折磨。
 8、在胚胎移植后两周,定时去抽血验血或是检验尿液,来确定着床、受孕情况,若是成功受孕当然很是高兴,要是失败,就需要重头再来,这是一件考验女性心理承受能力的事情。 受孕成功后,若体内移植的多个胚胎都发育良好,就会依据相关减胎政策,确保胎儿的正常发育和避免出现双胞胎、多胞胎的几率。
 9、在移植后的30天,会通过B超来检查胎儿的状况,之后就可以和自然受孕的妈妈们一样,通过正常怀孕,直至分娩,才算是完成了“试管婴儿”。 三位过来人揭秘试管婴儿后的感受 @往事如风:第一次移植冻胚没有着床,做了宫腔镜,也做了b超,还把输卵管结扎了,每天也会运动和泡脚,付出了这么多,为什么结果还是不能如愿。 @梦里花:今天官方抽血,确认移植失败了……从试管到现在胖了6斤,本来想着只要试管成功,胖点也无所谓的,可是并不是这样的,人胖了却没能好孕。这半年的努力,除了收获一身的肥肉,其他的什么也没有…
 @明天会更好:我和我老公结婚6年,做试管两促四移都没有成功,最后一次移植真的是满怀希望,一开始血值什么的都很好,翻倍也不错,可是一超的时候只有胎芽,我安慰自己可能是还早,第二次复查的时候结果连胎芽都没有了,这是多么的残忍,命中无子女就是我这样的人吧! 试管婴儿受孕成功后需要注意的事项 1、 注意饮食 受孕成功后,孕妈需要以清淡口味的饮食为主,当然要注意营养要补充营养,最低保证主食4两,40壳以上蛋白质搭配优质蛋白,如牛奶、鸡蛋、禽类和鱼肉等。 水果蔬菜每天要保证摄入量,保持充足的维生素,维生素A每天不超过5000-8000国际单位,维生素C应每天不超过1000mg,维生素D应每天不超过15mg,还需要按时服用400-600微克叶酸片,来预防胎儿的畸形。
 2、 保证良好的心情 受孕成功后,孕妈们最担心的事情莫过于中途流产,又要将之前所经历的痛楚和所做的努力再来一次,容易产生一些叫做的情绪,这就需要准妈妈蛮保持良好的心情,这样才更有利于胎儿的生长发育。 |